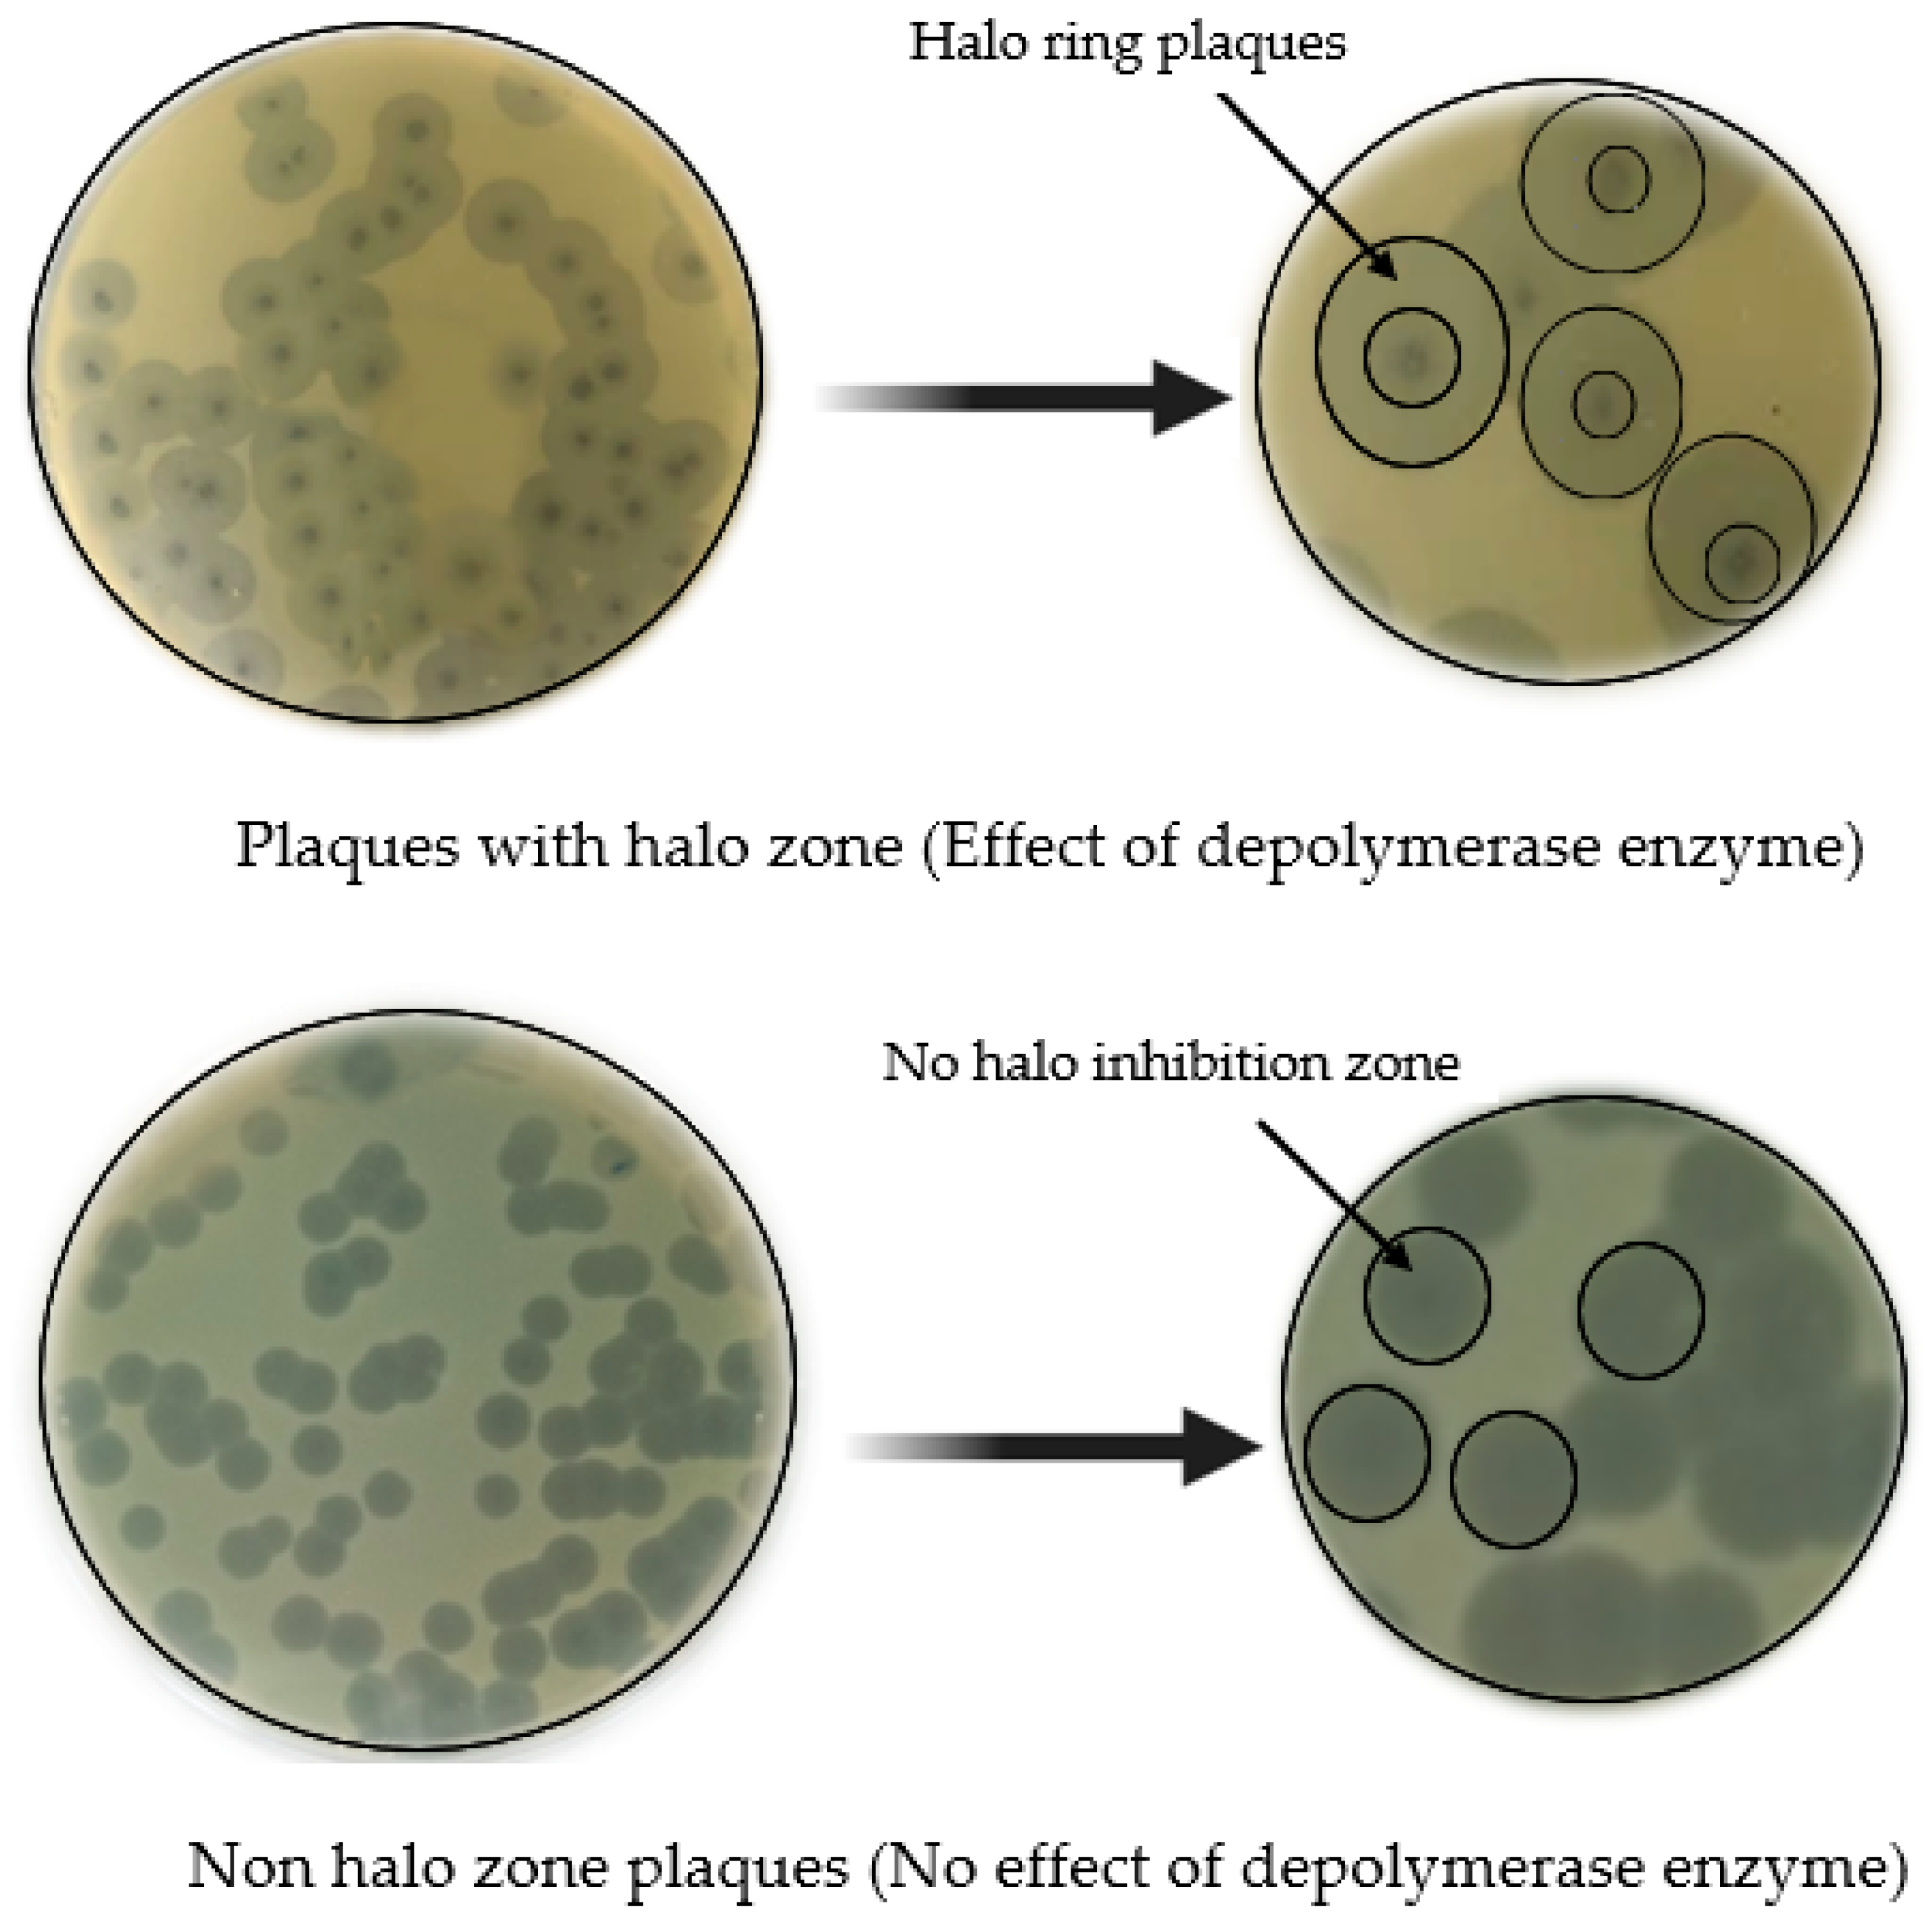
Life 13 00503 g004 Life 13 00503 g004

Beyond the Risk of Biofilms: An Up-and-Coming Battleground of Bacterial Life and Potential Antibiofilm Agents
Abstract
1. Introduction
2. Bacterial Biofilms
2.1. Bacterial Biofilm Formation
2.1.1. Adhesion
2.1.2. Microcolony Formation
2.1.3. Maturation
2.1.4. Dispersion
2.2. Antibiotic Resistance in Bacterial Biofilms
2.3. Antibiofilm Activities of Phages
2.3.1. Application of Mono Phages
2.3.2. Application of Phage Cocktails
2.3.3. Genetically Engineered Phages
2.3.4. Antibiofilm Activities of Phage-Derived Enzymes
- (i)
- Lysins
- (ii)
- Depolymerases
2.4. Other Natural Antibiofilm Agents
2.4.1. Plant Extracts
| Plants | Extract Type | Target Bacterium | Antibiofilm Effects | MIC | Reference |
|---|---|---|---|---|---|
| Piper betle leaf | Ethanol extract | E. coli ATCC25922, MRSA, S. aureus ATCC25923, | Inhibited biofilm production and promoted its eradication | 0.31–2.5 mg/mL | [118] |
| Dried ground materials of Camellia japonica and Thuja orientalis | Methanol extracts | S. mutans and C. albicans | Showed bactericidal activity and inhibited biofilm formation | 0.5 mg/mL | [119] |
| Leaves of the Myrtaceae family | Acetone crude leaf extracts | Bacillus cereus, E. fecalis, S. aureus, E. coli, P. aeruginosa, S. Typhimurium | Destroyed pre-formed biofilms and halted formation of biofilms | 0.04–0.08 mg/mL | [109] |
| Dried plant material of Prosopis laevigata, Opuntia ficus-indica, and Gutierrezia microcephala | Methanol extracts | Nosocomial microorganisms (K. pneumoniae, E. fecalis, E. coli, Stenotrophomonas maltophilia, S. aureus) | Showed both antimicrobial and antibiofilm activity against the tested strains | 0.7 mg/mL | [120] |
| Leaf extract of Pongamia pinnata | Methanol extract | Bacillus cereus, B. licheniformis | Showed antibiofilm activity | NA | [121] |
| Cladodes of Opuntia ficus-indica | Polyphenolic extracts | S. aureus | Prevent in vitro and in vivo biofilm formation | 2000 µg/mL | [122] |
| Leaves of Syncarpia hillii | Methanol extract | Staphylococcal species | Enhanced antibacterial and antibiofilm activities were observed | 0.63 mg/mL | [123] |
| Leaf extracts of Glochidion lanceolarium, Semecarpus anacardium, and Bridelia retusa | Phenolic extracts | P. aeruginosa, E. coli, and S. aureus | Inhibited biofilm formation | NA | [124] |
| Myrtus communis (Myrtenol) | Ethanol extract | S. aureus | It had antibiofilm activity and in silico results indicated a good pharmacokinetic profile | 128 µg/mL | [125] |
| Leaf extracts of Ocimum gratissimum, Alchornea laxiflora, Morinda lucida, Ficus exasperata, Jatropha gossypiifolia, and Acalypha wilkesiana | Acetone, methanol, and ethanol extracts | S. aureus, E. fecalis, Salmonella spp., E. coli, Campylobacter spp., and fungal species (Aspergillus fumigatus, Aspergillus flavus, and C. albicans | Showed good antibiofilm activity (>50%) against at least one organism | 0.03–0.15 mg/mL | [13] |
| Buds of Populus alba and Populus nigra extracts | Methanol, ethanol, and ethyl acetate extracts | S. aureus, E. fecalis, Bacillus subtilis, Listeria innocua, E. coli, P. aeruginosa, C. albicans, Saccharomyces cerevisiae | Showed antimicrobial and antibiofilm activities against the tested species | NA | [126] |
2.4.2. Honey
2.4.3. Essential Oils (EOs)
| Source of Essential Oils | Active Components | Antibiofilm Activities | MIC | Reference |
|---|---|---|---|---|
| Clove | Eugenol | L. monocytogenes and S. Enteritidis biofilms were reduced by 30.2% and 20.3%, respectively. | NA | [155] |
| Lemongrass (Cymbopogon flexuosus) | Citral | Bactericidal against S. aureus and Candida spp. and the biomass of their biofilms was reduced following treatment. | NA | [156] |
| Cymbopogon nardus and Geraniol | NA | S. aureus biofilm biomass was reduced up to 100% at 0.5–4 mg/mL concentrations. Number of viable cells was reduced at 0.25 and 1 mg/mL concentrations of EOCN and geraniol, respectively. | 0.5 and 0.25 mg/mL | [157] |
| Lippia origanoides | Thymol, carvacrol, phellandrene | Showed antibiofilm activity against the biofilms produced by E. coli O157:H7 and methicillin-resistant Staphylococcus aureus (MRSA). | 0.4–1.6 mg/mL | [158] |
| Lippia alba | Carvona, citral | E. coli O157:H7 and methicillin-resistant Staphylococcus aureus (MRSA). | >3 mg/mL | [158] |
| Satureja Montana | Carvacrol | P. aeruginosa, Streptococcus pyogenes, S. mutans, Streptococcus sanguis, Streptococcus salivarius, and E. feacalis Lactobacillus acidophilus. | 15.28 µg/mL–125.00 ± 8.66 µg/mL | [159] |
| Cinnamomum zeylanicum | Eugenol | Antibiofilm activity against the biofilms produced by Acinetobacter, K. pneumoniae, P. vulgaris, E. fecalis, S. aureus, and S. epidermidis. | 0.5–8 mg/mL | [160] |
| Rosmarinus officinalis | 1,8-cineole, α-pinene, borneol, camphor, βmyrcene | Showed antibiofilm activity towards S. epidermidis S61 and S. aureus ATCC 9144 biofilms. | 0.312–0.625 μL and 1.25–2.5 mL−1, respectively | [161] |
| Elletaria cardamomum | 1,8-cineole, linalool acetate, α-terpinyl acetate, sabinene, | Different concentrations of this essential oil prevented biofilm formation by E. coli O157:H7 and S. Typhimurium JSG 1748 at different rates. | 1% | [150] |
| Cinnamon (Cinnamomum verum) bark | Caryophyllene, β-thujene, 3-allyl-6-methoxyphenol, acetic acid cinnamyl ester, o-cymene, and α-phellandrene | Antibiofilm activity against maturation of oral biofilms (multi-species). | NA | [161] |
| Thyme plant | Thymol | 4096 and 2048 μg/mL concentration of this oil effectively inactivated an E. fecalis population in mature fecal biofilms by 7.20 and 5.75 log CFU/mL, respectively, at 30 min post-treatment. | 128 and 256 μg/mL | [39] |
| Clove essential oil (CEO) and oregano essential oil (OEO) | Eugenol, eugenol acetate, beta-caryophyllene alpha-humulene | Showed antibiofilm activity against Salmonella Derby biofilms. | 1/8 MIC | [162] |
| Laurelia sempervirens (Chilean laurel) | Safrol, methyl eugenol | Showed high antibiofilm activity against S. aureus biofilms at a concentration of 128 µgmL−1. | 64 µg mL−1 | [163] |
2.4.4. Biosurfactants
2.4.5. Maggot (Fly Larval) Therapy
3. Conclusions
Author Contributions
Funding
Institutional Review Board Statement
Informed Consent Statement
Data Availability Statement
Acknowledgments
Conflicts of Interest
References
- Marshall, K.C.; Stout, R.; Mitchell, R. Mechanism of the Initial Events in the Sorption of Marine Bacteria to Surfaces. J. Gen. Microbiol. 1971, 68, 337–348. [Google Scholar] [CrossRef]
- Characklis, W.G. Attached microbial growths—I. Attachment and growth. Water Res. 1973, 7, 1113–1127. [Google Scholar] [CrossRef]
- Geesey, G.G.; Mutch, R.; Costerton, J.W.; Green, R.B. Sessile bacteria: An important component of the microbial population in small mountain streams 1. Limnol. Oceanogr. 1978, 23, 1214–1223. [Google Scholar] [CrossRef]
- Fletcher, M.; Floodgate, G.D. An Electron-microscopic Demonstration of an Acidic Polysaccharide Involved in the Adhesion of a Marine Bacterium to Solid Surfaces. J. Gen. Microbiol. 1973, 74, 325–334. [Google Scholar] [CrossRef]
- Flemming, H.-C.; Wuertz, S. Bacteria and archaea on Earth and their abundance in biofilms. Nat. Rev. Microbiol. 2019, 17, 247–260. [Google Scholar] [CrossRef]
- de Vos, W.M. Microbial biofilms and the human intestinal microbiome. npj Biofilms Microbiomes 2015, 1, 15005. [Google Scholar] [CrossRef]
- Qvortrup, K.; Hultqvist, L.D.; Nilsson, M.; Jakobsen, T.H.; Jansen, C.U.; Uhd, J.; Andersen, J.B.; Nielsen, T.E.; Givskov, M.; Tolker-Nielsen, T. Small molecule anti-biofilm agents developed on the basis of mechanistic understanding of biofilm formation. Front. Chem. 2019, 7, 742. [Google Scholar] [CrossRef] [PubMed]
- Flemming, H.C. Wingender: The biofilm matrix. Nat Rev Microbiol 2010, 8, 623–633. [Google Scholar] [CrossRef]
- Branda, S.S.; Vik, Å.; Friedman, L.; Kolter, R. Biofilms: The matrix revisited. Trends Microbiol. 2005, 13, 20–26. [Google Scholar] [CrossRef]
- Zhang, L.; Liang, E.; Cheng, Y.; Mahmood, T.; Ge, F.; Zhou, K.; Bao, M.; Lv, L.; Li, L.; Yi, J. Is combined medication with natural medicine a promising therapy for bacterial biofilm infection. Biomed. Pharmacother 2020, 128, 110184. [Google Scholar] [CrossRef]
- Long, H.K.; Osterwalder, M.; Welsh, I.C.; Hansen, K.; Davies, J.O.; Liu, Y.E.; Koska, M.; Adams, A.T.; Aho, R.; Arora, N.; et al. Loss of Extreme Long-Range Enhancers in Human Neural Crest Drives a Craniofacial Disorder. Cell Stem Cell 2020, 27, 765–783.e14. [Google Scholar] [CrossRef] [PubMed]
- El-Atrees, D.M.; El-Kased, R.F.; Abbas, A.M.; Yassien, M.A. Characterization and anti-biofilm activity of bacteriophages against urinary tract Enterococcus faecalis isolates. Sci. Rep. 2022, 12, 13048. [Google Scholar] [CrossRef] [PubMed]
- Olawuwo, O.S.; Famuyide, I.M.; McGaw, L.J. Antibacterial and Antibiofilm Activity of Selected Medicinal Plant Leaf Extracts Against Pathogens Implicated in Poultry Diseases. Front. Veter- Sci. 2022, 9, 820304. [Google Scholar] [CrossRef] [PubMed]
- Asma, S.T.; Imre, K.; Morar, A.; Herman, V.; Acaroz, U.; Mukhtar, H.; Arslan-Acaroz, D.; Shah, S.R.A.; Gerlach, R. An overview of biofilm formation–combating strategies and mechanisms of action of antibiofilm agents. Life 2022, 12, 1110. [Google Scholar] [CrossRef]
- Rhimi, W.; Mohammed, M.A.; Zarea, A.A.K.; Greco, G.; Tempesta, M.; Otranto, D.; Cafarchia, C. Antifungal, antioxidant and antibiofilm activities of essential oils of Cymbopogon spp. Antibiotics 2022, 11, 829. [Google Scholar] [CrossRef]
- de Oliveira, L.H.; Trigueiro, P.; Souza, J.S.N.; de Carvalho, M.S.; Osajima, J.A.; da Silva-Filho, E.C.; Fonseca, M.G. Montmorillonite with essential oils as antimicrobial agents, packaging, repellents, and insecticides: An overview. Colloids Surf. B Biointerfaces 2022, 209, 112186. [Google Scholar] [CrossRef]
- Shapla, U.M.; Solayman, M.; Alam, N.; Khalil, M.I.; Gan, S.H. 5-Hydroxymethylfurfural (HMF) levels in honey and other food products: Effects on bees and human health. Chem. Cent. J. 2018, 12, 35. [Google Scholar] [CrossRef]
- Nadar, S.; Khan, T.; Patching, S.G.; Omri, A. Development of antibiofilm therapeutics strategies to overcome antimicrobial drug resistance. Microorganisms 2022, 10, 303. [Google Scholar] [CrossRef]
- Lu, J.; Cokcetin, N.N.; Burke, C.M.; Turnbull, L.; Liu, M.; Carter, D.A.; Whitchurch, C.B.; Harry, E.J. Honey can inhibit and eliminate biofilms produced by Pseudomonas aeruginosa. Sci. Rep. 2019, 9, 1–13. [Google Scholar] [CrossRef] [PubMed]
- Lu, L.; Hu, W.; Tian, Z.; Yuan, D.; Yi, G.; Zhou, Y.; Cheng, Q.; Zhu, J.; Li, M. Developing natural products as potential anti-biofilm agents. Chin. Med. 2019, 14, 1–17. [Google Scholar] [CrossRef]
- Topka-Bielecka, G.; Dydecka, A.; Necel, A.; Bloch, S.; Nejman-Faleńczyk, B.; Węgrzyn, G.; Węgrzyn, A. Bacteriophage-derived depolymerases against bacterial biofilm. Antibiotics 2021, 10, 175. [Google Scholar] [CrossRef]
- Jakubovics, N.S.; Goodman, S.D.; Mashburn-Warren, L.; Stafford, G.P.; Cieplik, F. The dental plaque biofilm matrix. Periodontology 2000 2021, 86, 32–56. [Google Scholar] [CrossRef] [PubMed]
- Fulaz, S.; Vitale, S.; Quinn, L.; Casey, E. Nanoparticle–Biofilm Interactions: The Role of the EPS Matrix. Trends Microbiol. 2019, 27, 915–926. [Google Scholar] [CrossRef]
- Dragoš, A.; Kovács, Á.T. The peculiar functions of the bacterial extracellular matrix. Trends Microbiol. 2017, 25, 257–266. [Google Scholar] [CrossRef] [PubMed]
- Guła, G.; Dorotkiewicz-Jach, A.; Korzekwa, K.; Valvano, M.A.; Drulis-Kawa, Z. Complex Signaling Networks Controlling Dynamic Molecular Changes in Pseudomonas aeruginosa Biofilm. Curr. Med. Chem. 2019, 26, 1979–1993. [Google Scholar] [CrossRef]
- Abebe, G.M. The Role of Bacterial Biofilm in Antibiotic Resistance and Food Contamination. Int. J. Microbiol. 2020, 2020, 1705814. [Google Scholar] [CrossRef]
- Brindhadevi, K.; LewisOscar, F.; Mylonakis, E.; Shanmugam, S.; Verma, T.N.; Pugazhendhi, A. Biofilm and Quorum sensing mediated pathogenicity in Pseudomonas aeruginosa. Process. Biochem. 2020, 96, 49–57. [Google Scholar] [CrossRef]
- Zhao, X.; Liu, X.; Xu, X.; Fu, Y.V. Microbe social skill: The cell-to-cell communication between microorganisms. Sci. Bull. 2017, 62, 516–524. [Google Scholar] [CrossRef]
- Tian, F.; Li, J.; Nazir, A.; Tong, Y. Bacteriophage—A Promising Alternative Measure for Bacterial Biofilm Control. Infect. Drug Resist. 2021, 14, 205–217. [Google Scholar] [CrossRef]
- Muhammad, M.H.; Idris, A.L.; Fan, X.; Guo, Y.; Yu, Y.; Jin, X.; Qiu, J.; Guan, X.; Huang, T. Beyond risk: Bacterial biofilms and their regulating approaches. Front. Microbiol. 2020, 11, 928. [Google Scholar] [CrossRef] [PubMed]
- Karygianni, L.; Ren, Z.; Koo, H.; Thurnheer, T. Biofilm matrixome: Extracellular components in structured microbial communities. Trends Microbiol. 2020, 28, 668–681. [Google Scholar] [CrossRef] [PubMed]
- Rumbaugh, K.P.; Sauer, K. Biofilm dispersion. Nat. Rev. Microbiol. 2020, 18, 571–586. [Google Scholar] [CrossRef]
- Srinivasan, R.; Santhakumari, S.; Poonguzhali, P.; Geetha, M.; Dyavaiah, M.; Xiangmin, L. Bacterial Biofilm Inhibition: A Focused Review on Recent Therapeutic Strategies for Combating the Biofilm Mediated Infections. Front. Microbiol. 2021, 12, 676458. [Google Scholar] [CrossRef] [PubMed]
- Funari, R.; Shen, A.Q. Detection and Characterization of Bacterial Biofilms and Biofilm-Based Sensors. ACS Sens. 2022, 7, 347–357. [Google Scholar] [CrossRef] [PubMed]
- Sharma, D.; Misba, L.; Khan, A.U. Antibiotics versus biofilm: An emerging battleground in microbial communities. Antimicrob. Resist. Infect. Control 2019, 8, 76. [Google Scholar] [CrossRef] [PubMed]
- Oliva, A.; Stefani, S.; Venditti, M.; Di Domenico, E.G. Biofilm-related infections in Gram-positive bacteria and the potential role of the long-acting agent dalbavancin. Front. Microbiol. 2021, 12, 749685. [Google Scholar] [CrossRef] [PubMed]
- Di Domenico, E.G.; Oliva, A.; Guembe, M. The current knowledge on the pathogenesis of tissue and medical device-related biofilm infections. Microorganisms 2022, 10, 1259. [Google Scholar] [CrossRef] [PubMed]
- Khan, J.; Tarar, S.M.; Gul, I.; Nawaz, U.; Arshad, M. Challenges of antibiotic resistance biofilms and potential combating strategies: A review. 3 Biotech 2021, 11, 169. [Google Scholar] [CrossRef]
- Liu, F.; Jin, P.; Gong, H.; Sun, Z.; Du, L.; Wang, D. Antibacterial and antibiofilm activities of thyme oil against foodborne multiple antibiotics-resistant Enterococcus faecalis. Poult. Sci. 2020, 99, 5127–5136. [Google Scholar] [CrossRef]
- Dale, J.L.; Cagnazzo, J.; Phan, C.Q.; Barnes, A.M.T.; Dunny, G.M. Multiple Roles for Enterococcus faecalis Glycosyltransferases in Biofilm-Associated Antibiotic Resistance, Cell Envelope Integrity, and Conjugative Transfer. Antimicrob. Agents Chemother. 2015, 59, 4094–4105. [Google Scholar] [CrossRef] [PubMed]
- Chua, S.L.; Yam, J.K.H.; Hao, P.; Adav, S.S.; Salido, M.M.; Liu, Y.; Givskov, M.; Sze, S.K.; Tolker-Nielsen, T.; Yang, L. Selective labelling and eradication of antibiotic-tolerant bacterial populations in Pseudomonas aeruginosa biofilms. Nat. Commun. 2016, 7, 10750. [Google Scholar] [CrossRef] [PubMed]
- Brackman, G.; Breyne, K.; De Rycke, R.; Vermote, A.; Van Nieuwerburgh, F.; Meyer, E.; Van Calenbergh, S.; Coenye, T. The Quorum Sensing Inhibitor Hamamelitannin Increases Antibiotic Susceptibility of Staphylococcus aureus Biofilms by Affecting Peptidoglycan Biosynthesis and eDNA Release. Sci. Rep. 2016, 6, 20321. [Google Scholar] [CrossRef]
- Singh, S.; Datta, S.; Narayanan, K.B.; Rajnish, K.N. Bacterial exo-polysaccharides in biofilms: Role in antimicrobial resistance and treatments. J. Genet. Eng. Biotechnol. 2021, 19, 140. [Google Scholar] [CrossRef]
- Wang, L.; Li, Y.; Wang, L.; Zhang, H.; Zhu, M.; Zhang, P.; Zhu, X. Extracellular polymeric substances affect the responses of multi-species biofilms in the presence of sulfamethizole. Environ. Pollut. 2018, 235, 283–292. [Google Scholar] [CrossRef]
- Colvin, K.M.; Gordon, V.; Murakami, K.; Borlee, B.R.; Wozniak, D.J.; Wong, G.C.L.; Parsek, M.R. The Pel Polysaccharide Can Serve a Structural and Protective Role in the Biofilm Matrix of Pseudomonas aeruginosa. PLOS Pathog. 2011, 7, e1001264. [Google Scholar] [CrossRef]
- Kaldalu, N.; Hauryliuk, V.; Turnbull, K.J.; La Mensa, A.; Putrinš, M.; Tenson, T. In vitro studies of persister cells. Microbiol. Mol. Biol. Rev. 2020, 84, 70. [Google Scholar] [CrossRef]
- Beloin, C.; Renard, S.; Ghigo, J.-M.; Lebeaux, D. Novel approaches to combat bacterial biofilms. Curr. Opin. Pharmacol. 2014, 18, 61–68. [Google Scholar] [CrossRef]
- Wood, T.K.; Knabel, S.J.; Kwan, B.W. Bacterial Persister Cell Formation and Dormancy. Appl. Environ. Microbiol. 2013, 79, 7116–7121. [Google Scholar] [CrossRef] [PubMed]
- Hall, C.W.; Mah, T.-F. Molecular mechanisms of biofilm-based antibiotic resistance and tolerance in pathogenic bacteria. FEMS Microbiol. Rev. 2017, 41, 276–301. [Google Scholar] [CrossRef] [PubMed]
- Papadovasilaki, M.; Oberthür, D.; Gessmann, R.; Sarrou, I.; Betzel, C.; Scoulica, E.; Petratos, K. Biophysical and enzymatic properties of aminoglycoside adenylyltransferase AadA6 from Pseudomonas aeruginosa. Biochem. Biophys. Rep. 2015, 4, 152–157. [Google Scholar] [CrossRef]
- Walters III, M.C.; Roe, F.; Bugnicourt, A.; Franklin, M.J.; Stewart, P.S. Contributions of antibiotic penetration, oxygen limitation, and low metabolic activity to tolerance of Pseudomonas aeruginosa biofilms to ciprofloxacin and tobramycin. Antimicrob. Agents Chemother. 2003, 47, 317–323. [Google Scholar] [CrossRef]
- Stokes, J.M.; Lopatkin, A.J.; Lobritz, M.A.; Collins, J.J. Bacterial Metabolism and Antibiotic Efficacy. Cell Metab. 2019, 30, 251–259. [Google Scholar] [CrossRef] [PubMed]
- Rao, Y.; Shang, W.; Yang, Y.; Zhou, R.; Rao, X. Fighting mixed-species microbial biofilms with cold atmospheric plasma. Front. Microbiol. 2020, 11, 1000. [Google Scholar] [CrossRef] [PubMed]
- Govaert, M.; Smet, C.; Walsh, J.L.; Van Impe, J.F.M. Dual-Species Model Biofilm Consisting of Listeria monocytogenes and Salmonella Typhimurium: Development and Inactivation With Cold Atmospheric Plasma (CAP). Front. Microbiol. 2019, 10, 2524. [Google Scholar] [CrossRef] [PubMed]
- Chen, Y.; Li, X.; Wang, S.; Guan, L.; Li, X.; Hu, D.; Gao, D.; Song, J.; Chen, H.; Qian, P. A Novel Tail-Associated O91-Specific Polysaccharide Depolymerase from a Podophage Reveals Lytic Efficacy of Shiga Toxin-Producing Escherichia coli. Appl. Environ. Microbiol. 2020, 86, 145. [Google Scholar] [CrossRef]
- Vukotic, G.; Obradovic, M.; Novovic, K.; Di Luca, M.; Jovcic, B.; Fira, D.; Neve, H.; Kojic, M.; McAuliffe, O. Characterization, antibiofilm, and depolymerizing activity of two phages active on carbapenem-resistant Acinetobacter baumannii. Front. Med. 2020, 7, 426. [Google Scholar] [CrossRef]
- Chegini, Z.; Khoshbayan, A.; Taati Moghadam, M.; Farahani, I.; Jazireian, P.; Shariati, A. Bacteriophage therapy against Pseudomonas aeruginosa biofilms: A review. Ann. Clin. Microbiol. Antimicrob. 2020, 19, 45. [Google Scholar] [CrossRef]
- Ferriol-González, C.; Domingo-Calap, P. Phages for biofilm removal. Antibiotics 2020, 9, 268. [Google Scholar] [CrossRef]
- Loponte, R.; Pagnini, U.; Iovane, G.; Pisanelli, G. Phage therapy in veterinary medicine. Antibiotics 2021, 10, 421. [Google Scholar] [CrossRef]
- Rakov, C.; Ben Porat, S.; Alkalay-Oren, S.; Yerushalmy, O.; Abdalrhman, M.; Gronovich, N.; Huang, L.; Pride, D.; Coppenhagen-Glazer, S.; Nir-Paz, R.; et al. Targeting Biofilm of MDR Providencia stuartii by Phages Using a Catheter Model. Antibiotics 2021, 10, 375. [Google Scholar] [CrossRef]
- Ben-Zaken, H.; Kraitman, R.; Coppenhagen-Glazer, S.; Khalifa, L.; Alkalay-Oren, S.; Gelman, D.; Ben-Gal, G.; Beyth, N.; Hazan, R. Isolation and characterization of Streptococcus mutans phage as a possible treatment agent for caries. Viruses 2021, 13, 825. [Google Scholar] [CrossRef]
- Rajabi, Z.; Kermanshahi, R.; Dallal, M.M.S.; Erfani, Y.; Ranjbar, R. Isolation of the bacteriophages inhibiting the expression of the genes involved in biofilm formation by Streptococcus mutans. Jundishapur J. Microbiol. 2021, 14, 7. [Google Scholar] [CrossRef]
- Kim, S.G.; Giri, S.S.; Yun, S.; Kim, S.W.; Han, S.J.; Kwon, J.; Oh, W.T.; Lee, S.B.; Park, Y.H.; Park, S.C. Two novel bacteriophages control multidrug-and methicillin-resistant Staphylococcus pseudintermedius biofilm. Front. Med. 2021, 8, 524059. [Google Scholar] [CrossRef] [PubMed]
- Tinoco, J.M.; Buttaro, B.; Zhang, H.; Liss, N.; Sassone, L.; Stevens, R. Effect of a genetically engineered bacteriophage on Enterococcus faecalis biofilms. Arch. Oral. Biol. 2016, 71, 80–86. [Google Scholar] [CrossRef]
- Nale, J.Y.; Clokie, M.R. Preclinical data and safety assessment of phage therapy in humans. Curr. Opin. Biotechnol. 2021, 68, 310–317. [Google Scholar] [CrossRef]
- Montso, P.K.; Mlambo, V.; Ateba, C.N. Efficacy of novel phages for control of multi-drug resistant Escherichia coli O177 on artificially contaminated beef and their potential to disrupt biofilm formation. Food Microbiol. 2020, 94, 103647. [Google Scholar] [CrossRef] [PubMed]
- Zeid, A.A.A.; Swelim, M.A.; Reda, F.M.; El Haveez, A.M.A.; Nasr-Eldin, M.A. Effectiveness of Four Lytic Phages Against Biofilm-Producing and Multidrug-Resistant Escherichia Coli. Benha J. Appl. Sci. 2021, 6, 53–65. [Google Scholar] [CrossRef]
- Zurabov, F.; Zhilenkov, E. Characterization of four virulent Klebsiella pneumoniae bacteriophages, and evaluation of their potential use in complex phage preparation. Virol. J. 2021, 18, 9. [Google Scholar] [CrossRef]
- Askoura, M.; Saed, N.; Enan, G.; Askora, A. Characterization of polyvalent bacteriophages targeting multidrug-resistant Klebsiella pneumonia with enhanced anti-biofilm activity. Appl. Biochem. Microbiol. 2021, 57, 117–126. [Google Scholar] [CrossRef]
- Abdurahman, M.; Tosun, I.; Durukan, I.; Khorshidtalab, M.; KILIÇ, A. Four Temperate bacteriophages from methicillin-resistant Staphylococcus aureus show broad bactericidal and biofilm removal activities. Kafkas Univ. Vet. Fak. Derg. 2021, 27, 29–36. [Google Scholar]
- Kifelew, L.G.; Warner, M.S.; Morales, S.; Thomas, N.; Gordon, D.L.; Mitchell, J.G.; Speck, P.G. Efficacy of lytic phage cocktails on Staphylococcus aureus and Pseudomonas aeruginosa in mixed-species planktonic cultures and biofilms. Viruses 2020, 12, 559. [Google Scholar] [CrossRef]
- Gutiérrez, D.; Briers, Y.; Rodríguez-Rubio, L.; Martínez, B.; Rodríguez, A.; Lavigne, R.; García, P. Role of the pre-neck appendage protein (Dpo7) from phage vB_SepiS-phiIPLA7 as an anti-biofilm agent in staphylococcal species. Front. Microbiol. 2015, 6, 1315. [Google Scholar] [CrossRef]
- Peng, H.; A Chen, I. Phage engineering and the evolutionary arms race. Curr. Opin. Biotechnol. 2020, 68, 23–29. [Google Scholar] [CrossRef]
- Chen, J.; Chen, Z.; Yuan, K.; Huang, Z.; Mao, M. Recombinant bacteriophage T4 Rnl1 impacts Streptococcus mutans biofilm formation. J. Oral Microbiol. 2020, 13, 1860398. [Google Scholar] [CrossRef] [PubMed]
- Guo, D.; Chen, J.; Zhao, X.; Luo, Y.; Jin, M.; Fan, F.; Park, C.; Yang, X.; Sun, C.; Yan, J.; et al. Genetic and Chemical Engineering of Phages for Controlling Multidrug-Resistant Bacteria. Antibiotics 2021, 10, 202. [Google Scholar] [CrossRef] [PubMed]
- Huang, Z.; Zhang, Z.; Tong, J.; Malakar, P.K.; Chen, L.; Liu, H.; Pan, Y.; Zhao, Y. Phages and their lysins: Toolkits in the battle against foodborne pathogens in the postantibiotic era. Compr. Rev. Food Sci. Food Saf. 2021, 20, 3319–3343. [Google Scholar] [CrossRef] [PubMed]
- Pinto, A.M.; Silva, M.D.; Pastrana, L.M.; Bañobre-López, M.; Sillankorva, S. The clinical path to deliver encapsulated phages and lysins. FEMS Microbiol. Rev. 2021, 45, fuab019. [Google Scholar] [CrossRef]
- Azeredo, J.; García, P.; Drulis-Kawa, Z. Targeting biofilms using phages and their enzymes. Curr. Opin. Biotechnol. 2021, 68, 251–261. [Google Scholar] [CrossRef]
- Duarte, A.C.; Fernández, L.; De Maesschalck, V.; Gutiérrez, D.; Campelo, A.B.; Briers, Y.; Lavigne, R.; Rodríguez, A.; García, P. Synergistic action of phage phiIPLA-RODI and lytic protein CHAPSH3b: A combination strategy to target Staphylococcus aureus biofilms. Npj Biofilms Microbiomes 2021, 7, 39. [Google Scholar] [CrossRef]
- Shen, Y.; Köller, T.; Kreikemeyer, B.; Nelson, D.C. Rapid degradation of Streptococcus pyogenes biofilms by PlyC, a bacteriophage-encoded endolysin. J. Antimicrob. Chemother. 2013, 68, 1818–1824. [Google Scholar] [CrossRef]
- Schuch, R.; Khan, B.K.; Raz, A.; Rotolo, J.A.; Wittekind, M. Bacteriophage lysin CF-301, a potent antistaphylococcal biofilm agent. Antimicrob Agents Chemother 2017, 61, 2666. [Google Scholar] [CrossRef] [PubMed]
- Cha, Y.; Son, B.; Ryu, S. Effective removal of staphylococcal biofilms on various food contact surfaces by Staphylococcus aureus phage endolysin LysCSA13. Food Microbiol. 2019, 84, 103245. [Google Scholar] [CrossRef]
- Yuan, Y.; Li, X.; Wang, L.; Li, G.; Cong, C.; Li, R.; Cui, H.; Murtaza, B.; Xu, Y. The endolysin of the Acinetobacter baumannii phage vB_AbaP_D2 shows broad antibacterial activity. Microb. Biotechnol. 2021, 14, 403–418. [Google Scholar] [CrossRef] [PubMed]
- Guo, M.; Feng, C.; Ren, J.; Zhuang, X.; Zhang, Y.; Zhu, Y.; Dong, K.; He, P.; Guo, X.; Qin, J. A novel antimicrobial endolysin, LysPA26, against Pseudomonas aeruginosa. Front. Microbiol. 2017, 8, 293. [Google Scholar] [CrossRef]
- Oliveira, H.; Thiagarajan, V.; Walmagh, M.; Sillankorva, S.; Lavigne, R.; Neves-Petersen, M.T.; Kluskens, L.D.; Azeredo, J. A thermostable Salmonella phage endolysin, Lys68, with broad bactericidal properties against gram-negative pathogens in presence of weak acids. PLoS ONE 2014, 9, e108376. [Google Scholar] [CrossRef] [PubMed]
- Meng, X.; Shi, Y.; Ji, W.; Meng, X.; Zhang, J.; Wang, H.; Lu, C.; Sun, J.; Yan, Y. Application of a Bacteriophage Lysin To Disrupt Biofilms Formed by the Animal Pathogen Streptococcus suis. Appl. Environ. Microbiol. 2011, 77, 8272–8279. [Google Scholar] [CrossRef]
- Linden, S.B.; Zhang, H.; Heselpoth, R.D.; Shen, Y.; Schmelcher, M.; Eichenseher, F.; Nelson, D.C. Biochemical and biophysical characterization of PlyGRCS, a bacteriophage endolysin active against methicillin-resistant Staphylococcus aureus. Appl. Microbiol. Biotechnol. 2014, 99, 741–752. [Google Scholar] [CrossRef]
- Son, J.-S.; Lee, S.-J.; Jun, S.Y.; Yoon, S.J.; Kang, S.H.; Paik, H.R.; Kang, J.O.; Choi, Y.-J. Antibacterial and biofilm removal activity of a podoviridae Staphylococcus aureus bacteriophage SAP-2 and a derived recombinant cell-wall-degrading enzyme. Appl. Microbiol. Biotechnol. 2009, 86, 1439–1449. [Google Scholar] [CrossRef]
- Sass, P.; Bierbaum, G. Lytic Activity of Recombinant Bacteriophage φ11 and φ12 Endolysins on Whole Cells and Biofilms of Staphylococcus aureus. Appl. Environ. Microbiol. 2007, 73, 347–352. [Google Scholar] [CrossRef]
- Ning, H.; Lin, H.; Wang, J.; He, X.; Lv, X.; Ju, L. Characterizations of the endolysin Lys84 and its domains from phage qdsa002 with high activities against Staphylococcus aureus and its biofilms. Enzym. Microb. Technol. 2021, 148, 109809. [Google Scholar] [CrossRef]
- Xu, J.; Yang, H.; Bi, Y.; Li, W.; Wei, H.; Li, Y. Activity of the chimeric lysin ClyR against common Gram-positive oral microbes and its anticaries efficacy in rat models. Viruses 2018, 10, 380. [Google Scholar] [CrossRef] [PubMed]
- Fursov, M.V.; Abdrakhmanova, R.O.; Antonova, N.P.; Vasina, D.V.; Kolchanova, A.D.; Bashkina, O.A.; Rubalsky, O.V.; Samotrueva, M.A.; Potapov, V.D.; Makarov, V.V.; et al. Antibiofilm Activity of a Broad-Range Recombinant Endolysin LysECD7: In Vitro and In Vivo Study. Viruses 2020, 12, 545. [Google Scholar] [CrossRef] [PubMed]
- Knecht, L.E.; Veljkovic, M.; Fieseler, L. Diversity and function of phage encoded depolymerases. Front. Microbiol. 2020, 10, 2949. [Google Scholar] [CrossRef]
- Wu, Y.; Wang, R.; Xu, M.; Liu, Y.; Zhu, X.; Qiu, J.; Liu, Q.; He, P.; Li, Q. A novel polysaccharide depolymerase encoded by the phage SH-KP152226 confers specific activity against multidrug-resistant Klebsiella pneumoniae via biofilm degradation. Front. Microbiol. 2019, 10, 2768. [Google Scholar] [CrossRef]
- Kassa, T.; Chhibber, S. Thermal treatment of the bacteriophage lysate of Klebsiella pneumoniae B5055 as a step for the purification of capsular depolymerase enzyme. J. Virol. Methods 2012, 179, 135–141. [Google Scholar] [CrossRef]
- Mahmud, S.A.; Roy, R.; Sugiokto, F.; Islam, N.; Lin, M.-D.; Lin, L.-C.; Lin, N.-T. Phage φAB6-Borne Depolymerase Combats Acinetobacter baumannii Biofilm Formation and Infection. Antibiotics 2021, 10, 279. [Google Scholar] [CrossRef]
- Olsen, N.M.; Thiran, E.; Hasler, T.; Vanzieleghem, T.; Belibasakis, G.N.; Mahillon, J.; Loessner, M.J.; Schmelcher, M. Synergistic removal of static and dynamic Staphylococcus aureus biofilms by combined treatment with a bacteriophage endolysin and a polysaccharide depolymerase. Viruses 2018, 10, 438. [Google Scholar] [CrossRef]
- Guo, Z.; Huang, J.; Yan, G.; Lei, L.; Wang, S.; Yu, L.; Zhou, L.; Gao, A.; Feng, X.; Han, W. Identification and characterization of Dpo42, a novel depolymerase derived from the Escherichia coli phage vB_EcoM_ECOO78. Front. Microbiol. 2017, 8, 1460. [Google Scholar] [CrossRef]
- Hernandez-Morales, A.C.; Lessor, L.L.; Wood, T.L.; Migl, D.; Mijalis, E.M.; Cahill, J.; Russell, W.K.; Young, R.F.; Gill, J.J. Genomic and biochemical characterization of Acinetobacter podophage petty reveals a novel lysis mechanism and tail-associated depolymerase activity. J. Virol. 2018, 92, 1064. [Google Scholar] [CrossRef]
- Mi, L.; Liu, Y.; Wang, C.; He, T.; Gao, S.; Xing, S.; Huang, Y.; Fan, H.; Zhang, X.; Yu, W.; et al. Identification of a lytic Pseudomonas aeruginosa phage depolymerase and its anti-biofilm effect and bactericidal contribution to serum. Virus Genes 2019, 55, 394–405. [Google Scholar] [CrossRef] [PubMed]
- Li, M.; Wang, H.; Chen, L.; Guo, G.; Li, P.; Ma, J.; Chen, R.; Du, H.; Liu, Y.; Zhang, W. Identification of a phage-derived depolymerase specific for KL47 capsule of Klebsiella pneumoniae and its therapeutic potential in mice. Virol. Sin. 2022, 57, 434–442. [Google Scholar] [CrossRef]
- Rice, C.J.; Kelly, S.A.; O’Brien, S.C.; Melaugh, E.M.; Ganacias, J.C.; Chai, Z.H.; Gilmore, B.F.; Skvortsov, T. Novel phage-derived depolymerase with activity against Proteus mirabilis biofilms. Microorganisms 2021, 9, 2172. [Google Scholar] [CrossRef] [PubMed]
- Pan, Y.-J.; Lin, T.-L.; Chen, C.-C.; Tsai, Y.-T.; Cheng, Y.-H.; Chen, Y.-Y.; Hsieh, P.-F.; Lin, Y.-T.; Wang, J.-T. Klebsiella Phage ΦK64-1 Encodes Multiple Depolymerases for Multiple Host Capsular Types. J. Virol. 2017, 91, 2457. [Google Scholar] [CrossRef]
- Latka, A.; Drulis-Kawa, Z. Advantages and limitations of microtiter biofilm assays in the model of antibiofilm activity of Klebsiella phage KP34 and its depolymerase. Sci. Rep. 2020, 10, 1–12. [Google Scholar] [CrossRef]
- Bansal, S.; Harjai, K.; Chhibber, S. Aeromonas punctata derived depolymerase improves susceptibility of Klebsiella pneumoniae biofilm to gentamicin. BMC Microbiol. 2015, 15, 119. [Google Scholar] [CrossRef] [PubMed]
- Romulo, A.; Zuhud, E.A.M.; Rondevaldova, J.; Kokoska, L. Screening of in vitro antimicrobial activity of plants used in traditional Indonesian medicine. Pharm. Biol. 2018, 56, 287–293. [Google Scholar] [CrossRef]
- de O Ribeiro, I.C.; Mariano, E.G.A.; Careli, R.T.; Morais-Costa, F.; de Sant’Anna, F.M.; Pinto, M.S.; de Souza, M.R.; Duarte, E.R. Plants of the Cerrado with antimicrobial effects against Staphylococcus spp. and Escherichia coli from cattle. BMC Vet. Res. 2018, 14, 32. [Google Scholar] [CrossRef]
- Quílez, A.; Fernández-Arche, M.; García-Giménez, M.; De la Puerta, R. Potential therapeutic applications of the genus Annona: Local and traditional uses and pharmacology. J. Ethnopharmacol. 2018, 225, 244–270. [Google Scholar] [CrossRef]
- Famuyide, I.M.; Aro, A.O.; Fasina, F.O.; Eloff, J.N.; McGaw, L.J. Antibacterial and antibiofilm activity of acetone leaf extracts of nine under-investigated south African Eugenia and Syzygium (Myrtaceae) species and their selectivity indices. BMC Complement. Altern. Med. 2019, 19, 141. [Google Scholar] [CrossRef]
- Adnan, M.; Patel, M.; Deshpande, S.; Alreshidi, M.; Siddiqui, A.J.; Reddy, M.N.; Emira, N.; De Feo, V. Effect of Adiantum philippense extract on biofilm formation, adhesion with its antibacterial activities against foodborne pathogens, and characterization of bioactive metabolites: An in vitro-in silico approach. Front. Microbiol. 2020, 11, 823. [Google Scholar] [CrossRef] [PubMed]
- Ravichandiran, V.; Shanmugam, K.; Anupama, K.; Thomas, S.; Princy, A. Structure-based virtual screening for plant-derived SdiA-selective ligands as potential antivirulent agents against uropathogenic Escherichia coli. Eur. J. Med. Chem. 2012, 48, 200–205. [Google Scholar] [CrossRef]
- Abraham, S.V.P.I.; Palani, A.; Ramaswamy, B.R.; Shunmugiah, K.P.; Arumugam, V.R. Antiquorum sensing and antibiofilm potential of Capparis spinosa. Arch. Med. Res. 2011, 42, 658–668. [Google Scholar] [CrossRef]
- Singh, B.N.; Singh, H.B.; Singh, A.; Singh, B.R.; Mishra, A.; Nautiyal, C.S. Lagerstroemia speciosa fruit extract modulates quorum sensing-controlled virulence factor production and biofilm formation in Pseudomonas aeruginosa. Microbiology 2012, 158, 529–538. [Google Scholar] [CrossRef]
- Harjai, K.; Kumar, R.; Singh, S. Garlic blocks quorum sensing and attenuates the virulence of Pseudomonas aeruginosa. FEMS Immunol. Med. Microbiol. 2010, 58, 161–168. [Google Scholar] [CrossRef]
- Carneiro, V.A.; Dos Santos, H.S.; Arruda, F.V.S.; Bandeira, P.N.; Albuquerque, M.R.J.R.; Pereira, M.O.; Henriques, M.; Cavada, B.S.; Teixeira, E.H. Casbane diterpene as a promising natural antimicrobial agent against biofilm-associated infections. Molecules 2010, 16, 190–201. [Google Scholar] [CrossRef]
- Taweechaisupapong, S.; Singhara, S.; Lertsatitthanakorn, P.; Khunkitti, W. Antimicrobial effects of Boesenbergia pandurata and Piper sarmentosum leaf extracts on planktonic cells and biofilm of oral pathogens. Pak. J. Pharm. Sci. 2010, 23, 2. [Google Scholar]
- Shahid, A.; Rasool, M.; Akhter, N.; Aslam, B.; Hassan, A.; Sana, S.; Rasool, M.H.; Khurshid, M. Innovative Strategies for the Control of Biofilm Formation in Clinical Settings. Bact. Biofilms 2019. [Google Scholar] [CrossRef]
- Saeloh, D.; Visutthi, M. Efficacy of Thai plant extracts for antibacterial and anti-biofilm activities against pathogenic bacteria. Antibiotics 2021, 10, 1470. [Google Scholar] [CrossRef]
- Choi, H.; Cheong, D.; Lim, H.; Kim, W.; Ham, M.; Oh, M.; Wu, Y.; Shin, H.; Kim, G. Antimicrobial and anti-biofilm activities of the methanol extracts of medicinal plants against dental pathogens Streptococcus mutans and Candida albicans. J. Microbiol. Biotechnol. 2017, 27, 1242–1248. [Google Scholar] [CrossRef]
- Sánchez, E.; Morales, C.R.; Castillo, S.; Leos-Rivas, C.; García-Becerra, L.; Martínez, D.M.O. Antibacterial and Antibiofilm Activity of Methanolic Plant Extracts against Nosocomial Microorganisms. Evidence-Based Complement. Altern. Med. 2016, 2016, 1–8. [Google Scholar] [CrossRef]
- Abraham, K.P.; Sreenivas, J.; Venkateswarulu, T.C.; Indira, M.; Babu, D.J.; Diwakar, T.; Prabhakar, K.V. Investigation of the potential antibiofilm activities of plant extracts. Int. J. Pharm. Pharm. Sci. 2012, 4, 282–285. [Google Scholar]
- Blando, F.; Russo, R.; Negro, C.; De Bellis, L.; Frassinetti, S. Antimicrobial and antibiofilm activity against Staphylococcus aureus of Opuntia ficus-indica (L.) Mill. cladode polyphenolic extracts. Antioxidants 2019, 8, 117. [Google Scholar] [CrossRef] [PubMed]
- Perera, M.M.; Dighe, S.N.; Katavic, P.L.; Collet, T.A. Antibacterial potential of extracts and phytoconstituents isolated from Syncarpia hillii leaves in vitro. Plants 2022, 11, 283. [Google Scholar] [CrossRef]
- Mohanta, Y.K.; Biswas, K.; Jena, S.K.; Hashem, A.; Abd_Allah, E.F.; Mohanta, T.K. Anti-biofilm and antibacterial activities of silver nanoparticles synthesized by the reducing activity of phytoconstituents present in the Indian medicinal plants. Front. Microbiol. 2020, 11, 1143. [Google Scholar] [CrossRef] [PubMed]
- Cordeiro, L.; Figueiredo, P.; Souza, H.; Sousa, A.; Andrade-Júnior, F.; Barbosa-Filho, J.; Lima, E. Antibacterial and antibiofilm activity of myrtenol against Staphylococcus aureus. Pharmaceuticals 2020, 13, 133. [Google Scholar] [CrossRef]
- Nassima, B.; Nassima, B.; Riadh, K. Antimicrobial and antibiofilm activities of phenolic compounds extracted from Populus nigra and Populus alba buds (Algeria). Braz. J. Pharm. Sci. 2019, 55. [Google Scholar] [CrossRef]
- Sindi, A.; Chawn, M.V.B.; Hernandez, M.E.; Green, K.; Islam, M.K.; Locher, C.; Hammer, K. Anti-biofilm effects and characterisation of the hydrogen peroxide activity of a range of Western Australian honeys compared to Manuka and multifloral honeys. Sci. Rep. 2019, 9, 17666. [Google Scholar] [CrossRef]
- Shirlaw, O.; Billah, Z.; Attar, B.; Hughes, L.; Qasaymeh, R.M.; Seidel, V.; Efthimiou, G. Antibiofilm Activity of Heather and Manuka Honeys and Antivirulence Potential of Some of Their Constituents on the DsbA1 Enzyme of Pseudomonas aeruginosa. Antibiotics 2020, 9, 911. [Google Scholar] [CrossRef]
- Kim, S.-Y.; Kang, S.-S. Anti-Biofilm Activities of Manuka Honey against Escherichia coli O157:H7. Korean J. Food Sci. Anim. Resour. 2020, 40, 668–674. [Google Scholar] [CrossRef]
- Sojka, M.; Valachova, I.; Bucekova, M.; Majtan, J. Antibiofilm efficacy of honey and bee-derived defensin-1 on multispecies wound biofilm. J. Med. Microbiol. 2016, 65, 337–344. [Google Scholar] [CrossRef]
- Lee, J.; Park, J.; Kim, J.; Neupane, G.P.; Cho, M.H.; Lee, C.; Lee, J. Low concentrations of honey reduce biofilm formation, quorum sensing, and virulence in Escherichia coli O157: H7. Biofouling 2011, 27, 1095–1104. [Google Scholar] [CrossRef]
- Merckoll, P.; Jonassen, T.Ø.; Vad, M.E.; Jeansson, S.L.; Melby, K.K. Bacteria, biofilm and honey: A study of the effects of honey on ‘planktonic’and biofilm-embedded chronic wound bacteria. Scand. J. Infect. Dis. 2009, 41, 341–347. [Google Scholar] [CrossRef]
- Nassar, H.M.; Li, M.; Gregory, R.L. Effect of Honey on Streptococcus mutans Growth and Biofilm Formation. Appl. Environ. Microbiol. 2012, 78, 536–540. [Google Scholar] [CrossRef]
- Basson, N.J.; Du Toit, I.J.; Grobler, S.R. Antibacterial action of honey on oral streptococci. S. Afr. Dent. J. 1994, 49, 339–341. [Google Scholar]
- Piotrowski, M.; Karpiński, P.; Pituch, H.; Van Belkum, A.; Obuch-Woszczatyński, P. Antimicrobial effects of Manuka honey on in vitro biofilm formation by Clostridium difficile. Eur. J. Clin. Microbiol. Infect. 2017, 36, 1661–1664. [Google Scholar] [CrossRef]
- Jervis-Bardy, J.; Foreman, A.; Bray, S.; Tan, L.; Wormald, P. Methylglyoxal-infused honey mimics the anti-Staphylococcus aureus biofilm activity of manuka honey: Potential implication in chronic rhinosinusitis. Laryngoscope 2011, 121, 1104–1107. [Google Scholar] [CrossRef]
- Ansari, M.J.; Al-Ghamdi, A.; Usmani, S.; Al-Waili, N.S.; Sharma, D.; Nuru, A.; Al-Attal, Y. Effect of Jujube Honey on Candida albicans Growth and Biofilm Formation. Arch. Med. Res. 2013, 44, 352–360. [Google Scholar] [CrossRef] [PubMed]
- Balázs, V.L.; Nagy-Radványi, L.; Filep, R.; Kerekes, E.; Kocsis, B.; Kocsis, M.; Farkas, Á. In vitro antibacterial and antibiofilm activity of Hungarian honeys against respiratory tract bacteria. Foods 2021, 10, 1632. [Google Scholar] [CrossRef] [PubMed]
- Kwakman, P.H.S.; de Boer, L.; Ruyter-Spira, C.P.; Creemers-Molenaar, T.; Helsper, J.P.F.G.; Vandenbroucke-Grauls, C.M.J.E.; Zaat, S.A.J.; Velde, A.A.T. Medical-grade honey enriched with antimicrobial peptides has enhanced activity against antibiotic-resistant pathogens. Eur. J. Clin. Microbiol. Infect. Dis. 2010, 30, 251–257. [Google Scholar] [CrossRef] [PubMed]
- Shaaban, H.A. Essential Oil as antimicrobial agents: Efficacy, stability, and safety issues for food application. Essent. Oils-Bioact. Compd. New Perspect. Appl. 2020, 1–33. [Google Scholar] [CrossRef]
- Wińska, K.; Mączka, W.; Łyczko, J.; Grabarczyk, M.; Czubaszek, A.; Szumny, A. Essential Oils as Antimicrobial Agents—Myth or Real Alternative? Molecules 2019, 24, 2130. [Google Scholar] [CrossRef]
- Nazzaro, F.; Fratianni, F.; De Martino, L.; Coppola, R.; De Feo, V. Effect of essential oils on pathogenic bacteria. Pharmaceuticals 2013, 6, 1451–1474. [Google Scholar] [CrossRef]
- Chimnoi, N.; Reuk-Ngam, N.; Chuysinuan, P.; Khlaychan, P.; Khunnawutmanotham, N.; Chokchaichamnankit, D.; Thamniyom, W.; Klayraung, S.; Mahidol, C.; Techasakul, S. Characterization of essential oil from Ocimum gratissimum leaves: Antibacterial and mode of action against selected gastroenteritis pathogens. Microb. Pathog. 2018, 118, 290–300. [Google Scholar] [CrossRef]
- Monica, B.; Ioan, S. Essential Oils from Plants. J. Biotechnol. Biomed. 2018, 1, 35–43. [Google Scholar]
- Al-Harrasi, A.; Bhatia, S.; Kaushik, D.; Ahmed, M.M.; Anwer, K.; Sharma, P.B. Mechanism of Action of Essential Oils as well as Its Components. In Role of Essential Oils in the Management of COVID-19; CRC Press: Boca Raton, FL, USA, 2022; pp. 179–186. [Google Scholar]
- Tariq, S.; Wani, S.; Rasool, W.; Shafi, K.; Bhat, M.A.; Prabhakar, A.; Shalla, A.H.; Rather, M.A. A comprehensive review of the antibacterial, antifungal and antiviral potential of essential oils and their chemical constituents against drug-resistant microbial pathogens. Microb. Pathog. 2019, 134, 103580. [Google Scholar] [CrossRef]
- Kwiatkowski, P.; Sienkiewicz, M.; Pruss, A.; Łopusiewicz, Ł.; Arszyńska, N.; Wojciechowska-Koszko, I.; Kilanowicz, A.; Kot, B.; Dołęgowska, B. Antibacterial and anti-biofilm activities of essential oil compounds against New Delhi Metallo-β-lactamase-1-producing uropathogenic Klebsiella pneumoniae strains. Antibiotics 2022, 11, 147. [Google Scholar] [CrossRef]
- Lim, A.C.; Tang, S.G.H.; Zin, N.M.; Maisarah, A.M.; Ariffin, I.A.; Ker, P.J.; Mahlia, T.M.I. Chemical Composition, Antioxidant, Antibacterial, and Antibiofilm Activities of Backhousia citriodora Essential Oil. Molecules 2022, 27, 4895. [Google Scholar] [CrossRef] [PubMed]
- Martínez, A.; Manrique-Moreno, M.; Klaiss-Luna, M.C.; Stashenko, E.; Zafra, G.; Ortiz, C. Effect of Essential Oils on Growth Inhibition, Biofilm Formation and Membrane Integrity of Escherichia coli and Staphylococcus aureus. Antibiotics 2021, 10, 1474. [Google Scholar] [CrossRef]
- Asghar, A.; Algburi, A.; Huang, Q.; Ahmad, T.; Zhong, H.; Javed, H.U.; Ermakov, A.M.; Chikindas, M.L. Anti-biofilm potential of Elletaria cardamomum essential oil against Escherichia coli O157: H7 and Salmonella Typhimurium JSG 1748. Front. Microbiol. 2021, 12, 749. [Google Scholar]
- Derakhshan, S.; Sattari, M.; Bigdeli, M. Effect of cumin (Cuminum cyminum) seed essential oil on biofilm formation and plasmid Integrity of Klebsiella pneumoniae. Pharmacogn. Mag. 2010, 6, 57. [Google Scholar]
- Chang, S.; Chen, P.; Chang, S. Antibacterial activity of leaf essential oils and their constituents from Cinnamomum osmophloeum. J. Ethnopharmacol. 2001, 77, 123–127. [Google Scholar] [CrossRef]
- Sadekuzzaman, M.; Yang, S.; Mizan, M.; Ha, S. Current and Recent Advanced Strategies for Combating Biofilms. Compr. Rev. Food Sci. Food Saf. 2015, 14, 491–509. [Google Scholar] [CrossRef]
- Coelho, F.A.B.L.; Pereira, M.O. Exploring new treatment strategies for Pseudomonas aeruginosa biofilm infections based on plant essential oils. In A. Mendez-Vilas, Microbial Pathogens and Strategies for Combating Them: Science, Technology and Education; Formatex: Badajoz, Spain, 2013; Volume 1, pp. 83–89. ISBN 978-84-942134-1-0. [Google Scholar]
- Somrani, M.; Debbabi, H.; Palop, A. Antibacterial and antibiofilm activity of essential oil of clove against Listeria monocytogenes and Salmonella enteritidis. Food Sci. Technol. Int. 2022, 28, 331–339. [Google Scholar] [CrossRef] [PubMed]
- Gao, S.; Liu, G.; Li, J.; Chen, J.; Li, L.; Li, Z.; Zhang, X.; Zhang, S.; Thorne, R.F.; Zhang, S. Antimicrobial Activity of Lemongrass Essential Oil (Cymbopogon flexuosus) and Its Active Component Citral Against Dual-Species Biofilms of Staphylococcus aureus and Candida Species. Front. Cell. Infect. Microbiol. 2020, 10, 603858. [Google Scholar] [CrossRef] [PubMed]
- Pontes, E.K.U.; Melo, H.M.; Nogueira, J.W.A.; Firmino, N.C.S.; de Carvalho, M.G.; Júnior, F.E.A.C.; Cavalcante, T.T.A. Antibiofilm activity of the essential oil of citronella (Cymbopogon nardus) and its major component, geraniol, on the bacterial biofilms of Staphylococcus aureus. Food Sci. Biotechnol. 2018, 28, 633–639. [Google Scholar] [CrossRef] [PubMed]
- Gómez-Sequeda, N.; Cáceres, M.; Stashenko, E.E.; Hidalgo, W.; Ortiz, C. Antimicrobial and antibiofilm activities of essential oils against Escherichia coli O157: H7 and methicillin-resistant Staphylococcus aureus (MRSA). Antibiotics 2020, 9, 730. [Google Scholar] [CrossRef]
- Nikolić, M.; Jovanović, K.K.; Marković, T.; Marković, D.; Gligorijević, N.; Radulović, S.; Soković, M. Chemical composition, antimicrobial, and cytotoxic properties of five Lamiaceae essential oils. Ind. Crops. Prod. 2014, 61, 225–232. [Google Scholar] [CrossRef]
- Aumeeruddy-Elalfi, Z.; Gurib-Fakim, A.; Mahomoodally, F. Antimicrobial, antibiotic potentiating activity and phytochemical profile of essential oils from exotic and endemic medicinal plants of Mauritius. Ind. Crop. Prod. 2015, 71, 197–204. [Google Scholar] [CrossRef]
- Jardak, M.; Elloumi-Mseddi, J.; Aifa, S.; Mnif, S. Chemical composition, anti-biofilm activity and potential cytotoxic effect on cancer cells of Rosmarinus officinalis L. essential oil from Tunisia. Lipids Health Dis. 2017, 16, 190. [Google Scholar] [CrossRef]
- Liu, Y.; Yan, Y.; Dong, P.; Ni, L.; Luo, X.; Zhang, Y.; Zhu, L. Inhibitory effects of clove and oregano essential oils on biofilm formation of Salmonella Derby isolated from beef processing plant. LWT 2022, 162, 113486. [Google Scholar] [CrossRef]
- Lobos, O.; Padilla, C.; Barrera, A.; Lopez-Cabana, Z.; Mora, C.; Abaca, P.; Carrasco-Sánchez, V. Antibiofilm and Antifungal Activities of Laurelia sempervirens (Chilean laurel) Essential Oil. Jundishapur J. Nat. Pharm. Prod. 2021, 16. [Google Scholar] [CrossRef]
- Patel, M.; Siddiqui, A.J.; Hamadou, W.S.; Surti, M.; Awadelkareem, A.M.; Ashraf, S.A.; Alreshidi, M.; Snoussi, M.; Rizvi, S.M.D.; Bardakci, F. Inhibition of bacterial adhesion and antibiofilm activities of a glycolipid biosurfactant from Lactobacillus rhamnosus with its physicochemical and functional properties. Antibiotics 2021, 10, 1546. [Google Scholar] [CrossRef] [PubMed]
- K Satputea, S.; G Banpurkar, A.; M Banat, I.; N Sangshetti, J.; H Patil, R.; N Gade, W. Multiple roles of biosurfactants in biofilms. Curr. Pharm. Des. 2016, 22, 1429–1448. [Google Scholar] [CrossRef] [PubMed]
- Paraszkiewicz, K.; Moryl, M.; Płaza, G.; Bhagat, D.; Satpute, S.K.; Bernat, P. Surfactants of microbial origin as antibiofilm agents. Int. J. Environ. Health Res. 2019, 31, 401–420. [Google Scholar] [CrossRef]
- Yan, J.; Bassler, B.L. Surviving as a community: Antibiotic tolerance and persistence in bacterial biofilms. Cell Host Microbe 2019, 26, 15–21. [Google Scholar]
- Yan, X.; Gu, S.; Cui, X.; Shi, Y.; Wen, S.; Chen, H.; Ge, J. Antimicrobial, anti-adhesive and anti-biofilm potential of biosurfactants isolated from Pediococcus acidilactici and Lactobacillus plantarum against Staphylococcus aureus CMCC26003. Microb. Pathog. 2018, 127, 12–20. [Google Scholar] [CrossRef]
- Giordani, B.; Costantini, P.E.; Fedi, S.; Cappelletti, M.; Abruzzo, A.; Parolin, C.; Foschi, C.; Frisco, G.; Calonghi, N.; Cerchiara, T. Liposomes containing biosurfactants isolated from Lactobacillus gasseri exert antibiofilm activity against methicillin resistant Staphylococcus aureus strains. Eur. J. Pharm. Biopharm. 2019, 139, 246–252. [Google Scholar] [CrossRef]
- Mishra, R.; Panda, A.K.; De Mandal, S.; Shakeel, M.; Bisht, S.S.; Khan, J. Natural anti-biofilm agents: Strategies to control biofilm-forming pathogens. Front. Microbiol. 2020, 11, 566325. [Google Scholar] [CrossRef]
- Phang, Z.H.; Khoo, S.S.; Gunasagaran, J.; Ahmad, T.S.T. Clinical outcome of Maggot Debridement Therapy followed by Negative Pressure Wound Therapy for chronic hand wound with Multi-Drug Resistant Organism infection: Two cases and review of the literature. J. Orthop. Surg. 2021, 29, 23094990211067302. [Google Scholar] [CrossRef]
- Wang, S.-Y.; Wang, J.-N.; Lv, D.-C.; Diao, Y.-P.; Zhang, Z. Clinical research on the bio-debridement effect of maggot therapy for treatment of chronically infected lesions. Orthop. Surg. 2010, 2, 201–206. [Google Scholar] [CrossRef]
- Baer, W.S. The Classic: The Treatment of Chronic Osteomyelitis With the Maggot (Larva of the Blow Fly). Clin. Orthop. Relat. Res. 2011, 469, 920–944. [Google Scholar] [CrossRef] [PubMed]
- Zubir, M.Z.M.; Holloway, S.; Noor, N.M. Maggot Therapy in Wound Healing: A Systematic Review. Int. J. Environ. Res. Public Health 2020, 17, 6103. [Google Scholar] [CrossRef]
- Van Der Plas, M.J.A.; Jukema, G.N.; Wai, S.-W.; Dogterom-Ballering, H.C.M.; Lagendijk, E.L.; Van Gulpen, C.; Van Dissel, J.T.; Bloemberg, G.V.; Nibbering, P.H. Maggot excretions/secretions are differentially effective against biofilms of Staphylococcus aureus and Pseudomonas aeruginosa. J. Antimicrob. Chemother. 2007, 61, 117–122. [Google Scholar] [CrossRef] [PubMed]
- Bohova, J.; Majtan, J.; Majtan, V.; Takac, P. Selective Antibiofilm Effects of Lucilia sericataLarvae Secretions/Excretions against Wound Pathogens. Evidence-Based Complement. Altern. Med. 2014, 2014, 1–9. [Google Scholar] [CrossRef]
- Harris, L.G.; Bexfield, A.; Nigam, Y.; Rohde, H.; Ratcliffe, N.A.; Mack, D. Disruption of Staphylococcus Epidermidis Biofilms by Medicinal Maggot Lucilia Sericata Excretions/Secretions. Int. J. Artif. Organs 2009, 32, 555–564. [Google Scholar] [CrossRef] [PubMed]
- Cazander, G.; van de Veerdonk, M.C.; Vandenbroucke-Grauls, C.M.J.E.; Schreurs, M.W.J.; Jukema, G.N. Maggot Excretions Inhibit Biofilm Formation on Biomaterials. Clin. Orthop. Relat. Res. 2010, 468, 2789–2796. [Google Scholar] [CrossRef]
- Liu, J.; Jiang, J.; Zong, J.; Li, B.; Pan, T.; Diao, Y.; Zhang, Z.; Zhang, X.; Lu, M.; Wang, S. Antibacterial and anti-biofilm effects of fatty acids extract of dried Lucilia sericata larvae against Staphylococcus aureus and Streptococcus pneumoniae in vitro. Nat. Prod. Res. 2021, 35, 1702–1705. [Google Scholar] [CrossRef]
- Brown, A.; Horobin, A.; Blount, D.G.; Hill, P.J.; English, J.; Rich, A.; Williams, P.M.; Pritchard, D.I. Blow fly Lucilia sericata nuclease digests DNA associated with wound slough/eschar and with Pseudomonas aeruginosa biofilm. Med. Vet. Entomol. 2012, 26, 432–439. [Google Scholar] [CrossRef]
- van der Plas, M.J.A.; Dambrot, C.; Dogterom-Ballering, H.C.M.; Kruithof, S.; van Dissel, J.T.; Nibbering, P.H. Combinations of maggot excretions/secretions and antibiotics are effective against Staphylococcus aureus biofilms and the bacteria derived therefrom. J. Antimicrob. Chemother. 2010, 65, 917–923. [Google Scholar] [CrossRef]
- Becerikli, M.; Wallner, C.; Dadras, M.; Wagner, J.M.; Dittfeld, S.; Jettkant, B.; Gestmann, F.; Mehlhorn, H.; Mehlhorn-Diehl, T.; Lehnhardt, M.; et al. Maggot Extract Interrupts Bacterial Biofilm Formation and Maturation in Combination with Antibiotics by Reducing the Expression of Virulence Genes. Life 2022, 12, 237. [Google Scholar] [CrossRef]
- Arora, S.; Baptista, C.; Lim, C.S. Maggot metabolites and their combinatory effects with antibiotic on Staphylococcus aureus. Ann. Clin. Microbiol. Antimicrob. 2011, 10, 1–8. [Google Scholar] [CrossRef] [PubMed]
- Cazander, G.; Pawiroredjo, J.S.; Vandenbroucke-Grauls, C.M.; Schreurs, M.W.; Jukema, G.N. Synergism between maggot excretions and antibiotics. Wound Repair Regen. 2010, 18, 637–642. [Google Scholar] [CrossRef] [PubMed]

| Phage (Endolysin) | Host Bacterium | Antibiofilm Activity | Reference |
|---|---|---|---|
| PA26 (LysPA26) | P. aeruginosa | Reduced the cells in the P. aeruginosa biofilm by 1- to 2-log CFU and destroyed the biofilm matrix. | [84] |
| phi68 (Lys68) | Salmonella | Reduced biofilms when coupled with malic or citric acid. | [85] |
| C1(PlyC) | Streptococcus pyogenes | Degraded biofilm matrix. | [80] |
| SMP (LysSMP) | Streptococcus suis | Efficient towards 32 biofilm-forming strains and >80% destruction of biofilms resulted | [86] |
| CSA13 (LysCSA13) | Staphylococcus | Destroyed the Staphylococcus biofilms on glass, stainless steel, and polystyrene surfaces. The mass of the biofilms was reduced by about 80–90%. | [82] |
| GRCS (PlyGRCS) | Staphylococcus | Active against planktonic and biofilm forms of MRSA. | [87] |
| Phi SAP-2 and 11 (LysSAP-2 and LysPhi11) | Staphylococcus | Eliminated whole biofilms created on polystyrene surfaces. | [88,89] |
| Phi84 (Lys84) | S. aureus | Approximately 90% of the biofilms of S. aureus were destroyed. | [90] |
| ClyR (LysClyR) | S. sobrinus and S. mutans | Reduced the viable cell counts in 72 h aged S. sobrinus and S. mutans biofilms following treatment at a concentration of 50 µg/mL, for 5 min. | [91] |
| ECD7 (LysECD7) | E. coli | Showed antibiofilm activity towards a wide range of bacterial biofilms including biofilms of K. pneumoniae Ts 141-14 clinical isolate. | [92] |
| Phages | Family | Depolymerase Enzyme | Targeted Species for Antibiofilm Activity | Reference |
|---|---|---|---|---|
| vB_EcoM_ECOO78 | Myoviridae | Dpo42 | E. coli (Clinical isolate) | [98] |
| PHB19 (T7-like phage) | NA | Dep6 | Shiga toxin-producing E. coli (STEC) | [55] |
| Petty | Podoviridae | Dpo1 | A. nosocomialis and A. baumannii | [99] |
| IME180 | Zobellviridae | NA | P. aeruginosa | [100] |
| Phage P560 | Podoviridae | P560dep | KL47 type K. pneumoniae | [101] |
| vB_PmiS_PM-CJR | Siphoviridae | NA | P. mirabilis BB2000 | [102] |
| ΦK64-1 | Myoviridae | Multiple depolymerases | Klebsiella capsular types | [103] |
| KP34 | Podoviridae | KP34p57 | K. pneumoniae | [104] |
| NA | NA | Aeromonas punctata-derived depolymerase | K. pneumoniae | [105] |
| ISTD and NOVI | Myoviridae | NA | ISTD resulted in a 2- and 3.5-log decline in planktonic and viable bacterial cells in the biofilm and planktonic cells, respectively. | [56] |
Disclaimer/Publisher’s Note: The statements, opinions and data contained in all publications are solely those of the individual author(s) and contributor(s) and not of MDPI and/or the editor(s). MDPI and/or the editor(s) disclaim responsibility for any injury to people or property resulting from any ideas, methods, instructions or products referred to in the content. |
© 2023 by the authors. Licensee MDPI, Basel, Switzerland. This article is an open access article distributed under the terms and conditions of the Creative Commons Attribution (CC BY) license (https://creativecommons.org/licenses/by/4.0/).
Share and Cite
Zeineldin, M.; Esmael, A.; Al-Hindi, R.R.; Alharbi, M.G.; Ashenafi Bekele, D.; Teklemariam, A.D. Beyond the Risk of Biofilms: An Up-and-Coming Battleground of Bacterial Life and Potential Antibiofilm Agents. Life 2023, 13, 503. https://doi.org/10.3390/life13020503
Zeineldin M, Esmael A, Al-Hindi RR, Alharbi MG, Ashenafi Bekele D, Teklemariam AD. Beyond the Risk of Biofilms: An Up-and-Coming Battleground of Bacterial Life and Potential Antibiofilm Agents. Life. 2023; 13(2):503. https://doi.org/10.3390/life13020503
Chicago/Turabian StyleZeineldin, Mohamed, Ahmed Esmael, Rashad R. Al-Hindi, Mona G. Alharbi, Debebe Ashenafi Bekele, and Addisu D. Teklemariam. 2023. "Beyond the Risk of Biofilms: An Up-and-Coming Battleground of Bacterial Life and Potential Antibiofilm Agents" Life 13, no. 2: 503. https://doi.org/10.3390/life13020503
APA StyleZeineldin, M., Esmael, A., Al-Hindi, R. R., Alharbi, M. G., Ashenafi Bekele, D., & Teklemariam, A. D. (2023). Beyond the Risk of Biofilms: An Up-and-Coming Battleground of Bacterial Life and Potential Antibiofilm Agents. Life, 13(2), 503. https://doi.org/10.3390/life13020503

